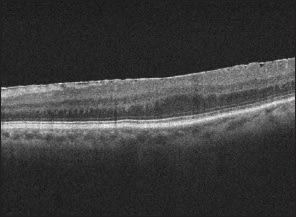

Retinal Imaging Modalities: Advantages and Limitations for Clinical Practice
Experts share their insights on selecting the appropriate option and obtaining the best results.
Khizer R. Khaderi, MD, MPH • K. Arsalaan Ahmed, BA • Jesse L. Berry, MD • Leanne T. Labriola, DO • Rich Cornwell, CRA, OCT-C
Today, ophthalmologists have a vast array of imaging tools to choose from—sophisticated devices that would have astonished our forebears in their day—but sometimes this abundance of options can be nearly as much a curse as a blessing. It requires the practice to invest in many costly technologies and to ensure that both physicians and technical staff are well trained in their use. Appropriately weighing the impact of imaging results on patient care decisions can also pose a challenge.
The intention of this article is not to provide an all-encompassing review of current technology, but rather to focus on the most common modalities, their inherent advantages and disadvantages, and how to optimize their use in clinical practice. We also will take a look at devices that prove best for imaging a few common pathologies.
HISTORY OF OCULAR IMAGING
A brief review of the history of ocular imaging permits a better understanding of the technology of today. Hermann von Helmholtz's invention of the direct ophthalmoscope in 1851 gave birth to the field of ocular imaging.1 For the first time, physicians were able to examine the retina in vivo rather than as a post-mortem specimen. Ocular imaging took another great step forward in 1961 when Novotny and Davis used fluorescein dye to image the retinal circulation. This technique, known as fluorescein angiography (FA), advanced ophthalmologists' understanding of vascular disease of the retina.2
Use of light filters necessary to obtain the images with fluorescein dye inadvertently led to the discovery of another retinal imaging technique that is commonplace today—fundus autofluorescence (FAF).3 Prior to injection of the dye, the natural fluorophores of lipofuscin granules hyperfluorescence in the retinal pigment epithelium. Fundus images that capture FAF are now used to study RPE changes in diseases such as macular degeneration and pattern dystrophies.
The next major breakthrough came about in the 1990s, when optical coherence tomography was invented and provided a non-invasive, radiation-free technique to precisely visualize the layers of the retina—something heretofore done only on pathology slides.4 Needless to say, OCT has become an indispensable tool in virtually all retina practices.
RETINAL IMAGING IN 2011
Fundus photography still remains an important imaging tool. There are two methods for capturing fundus photographs: digital fundus photography and confocal scanning laser ophthalmoscopy (cSLO). A digital camera captures a single image of the fundus, whereas cSLO uses laser light projected through a pinhole aperture that isolates a single wavelength to capture an image of the retina point by point. Adjusting the distance of the pinhole aperture captures different depths, and scans are obtained in a raster pattern. cSLO uses lasers of different wavelengths to add false color to the fundus image; however, digital fundus photography captures a truer color image. cSLO can make it more difficult for patients to stay still during image capture due to the laser light intensity, but fast acquisition speeds and after-image processing help correct movement artifacts. cSLOs can use longer wavelengths, which make them ideal to capture images for FAF and indocyanine green (ICG) angiograms.5
The two techniques for imaging vasculature are FA and ICG. A combination of phthalic acid with the plant resin resorcinol is used as the dye for FA, which fluoresces at a peak around 530 nm.6 Fluorescein leaks from damaged retinal vessels and can be used for evaluation of macular edema, venous occlusions and diabetic retinopathy. It delineates areas of choroidal nonperfusion in diabetic retinopathy and vascular leakage in choroidal neovascular membranes. ICG uses a tricarbocyanine dye that has a fluorescence peak around 800 nm. It is highly protein-bound and thus stays within choroidal vasculature better than fluorescein, which permits much-improved evaluation of the choroid. This advantage has made ICG the gold standard for diagnosis of the choroidopathies, including central serous retinopathy. ICG has milder side effects than FA for the most part; however, since it is iodine based, it is contraindicated in patients with iodine allergy or seafood allergy due to cross-reaction.7
Optical coherence tomography has quickly become a mainstay of retinal imaging for ophthalmologists. OCT systems are based on the principle of interferometry, which is similar to ultrasound except that near-infrared light (810 nm) replaces sound as the medium that is reflected as backscatter to create an image.8 Initially, OCT images were captured with time-domain OCTs (TD-OCT) but the next iteration came soon after with spectral-domain devices (SD-OCT). They provide sharper resolution of retinal layers and faster image-capture speeds than time-domain, and have found increased adoption in clinical practice. Recent research has lead to the advent of the novel frequency-domain OCT (FD-OCT) devices, which provide yet another significant improvement in resolution and speed.
SD-OCT differs from its predecessor because of its use of the Fourier mathematical transformation, which can sum a single periodic function into a series of sinusoidal functions. Once applied to the OCT, the Fourier transformation allows the simultaneous measurement of light reflection in the SD-OCT, compared to the sequential measurement in TD-OCT. The net result is an improvement in resolution of images from 10 µm to 1 µm, which has allowed detection of small cystic changes such as those seen early in the pathogenesis of wet AMD.9 The FD-OCT, though not yet available for widespread use, may well have the broadest application in clinical practice of the three OCT systems. Whereas SD-OCT uses a broadband light source and a spectrometer, the FD-OCT utilizes a wavelength-swept laser source. This change allows an improvement from the 40 kHz readout rates of the SD-OCTs to repetition rates as high as 370 kHz in the FD-OCTs. Clinically, the potential of the FD-OCTs is vast because of their wide fields of view, and they have found such far-reaching uses as imaging of coronary arteries and esophageal epithelium.10
Modifications of cSLO technology have led to innovative devices including the Optos Optomap SLO and the Nidek F10 SLO. The Optomap device uses confocal imaging in combination with an angled mirror to capture an ultra-widefield imaging of the retinal periphery with an almost 200° angle and 1984x1984 pixel resolution through a non-mydriatic pupil. Most Optomap devices have two laser wavelengths: red (633 nm) and green (532 nm). However, some devices have added blue-light laser to capture FA images as well.11
The Nidek F10 is another SLO imaging device that uses confocal optical principles, but combines them with multiple wavelengths and various sized apertures to create unique fundus images. One feature of the F10 is the use of a pinhole aperture with a central stop that allows light to be collected off-axis, which creates an artificial three-dimensional-like image. The full application of this device is not known but currently is being studied in patients with diabetic cystoid macular edema and retinoschisis.12
Figure 1 provides a summary of the advantages and limitations of each of these modalities. Figure 2 presents four of the most common pathologies seen in practice, discussed in terms of optimizing usage of tools available in the clinic. Lastly, Table 1 includes a practical list of guidelines and pointers. We hope these materials will be of value to you in enhancing your use of imaging technology. RP
Figure 1. Comparisons of Imaging Techniques
1. cSLO vs. Digital Fundus Photo

Advantages: Excellent contrast and detail; some cSLOs include OCT.
Limitations: Image quality more susceptible to media opacities, motion artifact and image processing; false color.
Optimal Uses: FAF, with ICG.

Advantages: Single image capture.
Limitations: Pupillary dilation usually needed.
Optimal Uses: Pigmented lesions, with FA.
2. FA vs. ICG

Advantages: Evaluate proliferative diseases of the retina and choroid.
Limitations: Poor view of choroidal vasculature; invasive—requires injection.
Optimal Uses: Diabetic retinopathy, CNV, vein occlusion.

Advantages: Imaging of choroidal vessels.
Limitations: Iodine-based dye, contraindicated if allergy.
Optimal Uses: Polypoidal CNV, CSCR.
3. Time-domain vs. Spectral-domain OCT

Advantages: User-friendly; less expensive.
Limitations: Lower resolution (10 µm); poor resolution of retinal layers; slower image capture; no eye tracking feature
Optimal Uses: Macular pathologies.

Advantages: Significantly improved resolution (1 µm); more images taken; eye tracking feature.
Limitations: More expensive; subject to inversion artifact.
Optimal Uses: Any cystic macular changes, ERM, VMT, following response to anti-VEGF agents.
4. Nidek F10 SLO vs. Spectralis SLO

Advantages: 3D-like image.
Limitations: No OCT modality; no normative database.
Optimal Uses: Minimally elevated lesions such as CME and macular schisis.

Advantages: Has OCT modality; good resolution of outer retina and choroid.
Limitations: Limited aspect ratio; limited normative database.
Optimal Uses: FAF and angiography (both FA and ICG).
Figure 2. Optimal Techniques for Common Pathologies
1. Wet AMD: OCT vs. FA with SLO

Most Optimal Technique
Advantages: Allows for quantification of retinal thickness; easy and quick; non-invasive.
Limitations: Need SD-OCT to see small (<10 µm) lesions.

Alternative Technique
Advantages: Follow leakage; classify NV membranes as classic or occult.
Limitations: Longer test; invasive; requires more patient cooperation; may not see anti-VEGF response as clearly.
2. Proliferative DR: FA vs. OCT

Most Optimal Technique
Advantages: See areas of NV and choroidal nonperfusion; used to target laser therapy.
Limitations: Longer test; invasive; requires more patient cooperation; may not see anti-VEGF response as clearly.

Alternative Technique
Advantages: Quantification of diabetic macular edema.
Limitations: Cannot visualize NV or non-perfusion; only captures macula, not the periphery.
3. Chronic CSR: FAF vs. FA

Most Optimal Technique
Advantages: Shows classic gutter appearance for CSCR; fully captures RPE disruption.
Limitations: Does not show active source of leakage or “hot spot”; does not show extent of SRF; uses blue light.

Alternative Technique
Advantages: Technique is appropriate for imaging both acute and chronic CSR.
Limitations: Invasive; adverse reaction to dye.
4. Epiretinal Membrane: OCT vs. Digital Fundus Photo
Most Optimal Technique
Advantages: Comparative measurements of progression; better analysis of complications with macular pucker and macular hole.
Limitations: Cannot see entire extent of surface over which puckering may occur.

Alternative Technique
Advantages: Can see surface area over which puckering may occur.
Limitations: Cannot quantify membrane thickness and presence of edema.

REFERENCES
1. von Helmholtz HLF. Beschreibung eines Augenspiegels. Berlin, Germany: A Förstner Sche Verlagsbuchhandlung; 1851.
2. Novotny HR, Alvis DL. A method of photographing fluorescence in circulating blood in the human retina. Circulation. 1961;24:82-86.
3. Machemer R, Norton EW, Gass JD, Choromokos E. Pseudofluorescence–a problem in interpretation of fluorescein angiograms. Am J Ophthalmol. 1970;70:1-10.
4. Huang D, Swanson EA, Lin CP, et al. Optical coherence tomography. Science 1991;254:1178-1181.
5. Yanuzzi LA, Ober MD, Slakter JS, et al. Ophthalmic fundus imaging: today and beyond. Am J Ophthalmol. 2004;137:511-524.
6. Blacharski, PA. 25 Years of fluorescein angiography. Arch Ophthalmol. 1985;103:1301-1302.
7. Stanga PE, Lim JI, Hamilton P. Indocyanine green angiography in chorioretinal diseases: indications and interpretation. Ophthalmology. 2003;110:15-21.
8. Bennet TJ, Barry CJ. Ophthalmic imaging today: an ophthalmic photographer's viewpoint—a review. Clin Exp Ophthalmol. 2009;37:2-13.
9. Kiernan DF, Mieler WF, Hariprasad SM. Spectral-domain optical coherence tomography: a comparison of modern high-resolution retinal imaging systems. Am J Ophthalmol. 2010;149:18-31.
10. Bouma BE, Youn SH, Vakoc BJ, et al. Fourier-domain optical coherence tomography: recent advances toward clinical utility. Curr Opin Biotechnol. 2009;20:111-118.
11. Meyer CH, Saxena S. Non-mydriatic imaging of a giant retinal tear with the optos optomap panorama 200MA. Clin Exp Ophthalmol. 2010;38:427-430.
12. Tanaka Y, Shimada N, Ohno-Matsui K, et al. Retromode retinal imaging of macular retinoschisis in highly myopic eyes. Am J Ophthalmol. 2010;149: 635-640.
| All authors are affiliated with the Doheny Eye Institute and the department of ophthalmology at Keck School of Medicine, University of Southern California. No authors in this paper have any financial or proprietary interest in a product, method or material published in this manuscript. Dr. Khaderi can be reached at kkhaderi@doheny.org. |








